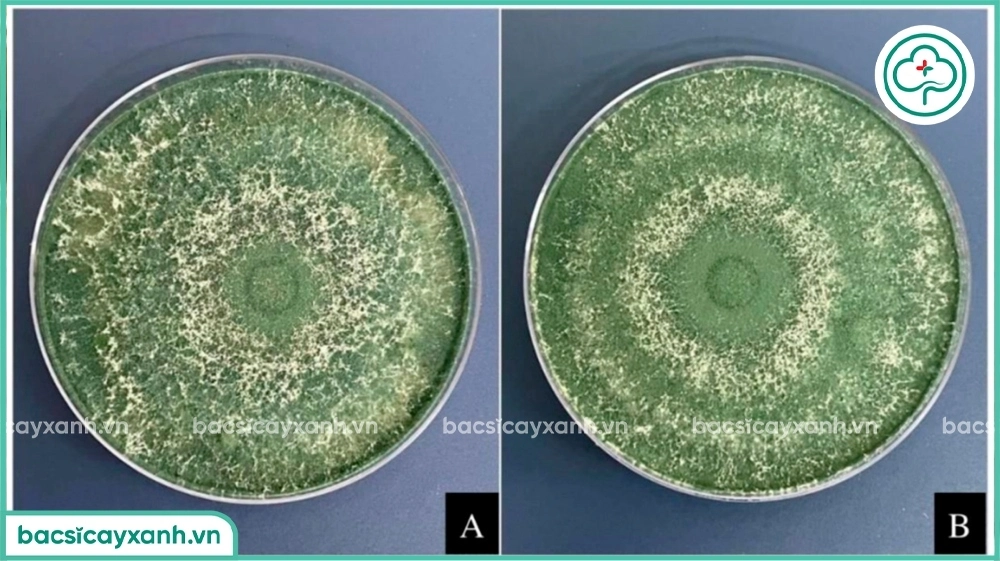
Tăng sinh khối nấm trichoderma

Nấm Trichoderma có nhiều công dụng quan trọng trong nông nghiệp được sử dụng như một phương pháp sinh học hiệu quả và tiết kiệm. Là một loại nấm đối kháng có lợi, giúp kiểm soát nấm bệnh hại (như Fusarium, Rhizoctonia, Phytophthora), cải thiện đất đai, phân hủy chất hữu cơ, diệt tuyến trùng, tăng sức đề kháng cho cây và giảm sử dụng phân bón hóa học.
Tác dụng chính của nấm Trichoderma
- Kiểm soát nấm bệnh gây hại: Nấm trichoderma tiêu diệt và kiểm soát các loại nấm gây hại thông qua ba cơ chế hoạt động tương hỗ lẫn nhau: ký sinh, tiết chất kháng nấm và cạnh tranh dinh dưỡng. Được ứng dụng diệt nấm gây vàng lá, thối rễ, chết nhanh/chậm, xì mủ (trên cây cà phê, sầu riêng, tiêu, bơ, lúa, rau màu).
- Kích kháng và bảo vệ bộ rễ của cây: Ức chế, phân huỷ vi sinh vật gây hại tại vùng rễ, kiểm soát và bảo vệ bộ rễ cây trồng. Kích thích cây trồng tự sản xuất các chất giúp tăng cường sức đề kháng.
- Kích thích sinh trưởng của cây trồng, cải tạo đất: Thúc đẩy quá trình trao đổi chất diễn ra mạnh mẽ hơn. Phân giải một số chất hữu cơ trong đất, giúp đất trở nên tơi xốp, tăng độ phì nhiêu.
- Phân hủy hữu cơ: Phân giải các chất hữu cơ và xác bã thực vật, ủ phân chuồng, phân xanh, rơm rạ, vỏ bã cà phê. Trichoderma giúp diệt các mầm bệnh trong nguyên liệu và giảm mùi hôi trong quá trình ủ.

Cách sử dụng Trichoderma tưới cây

| Đối tượng cây trồng | Mục đích | Tỷ lệ pha (cho 1kg chế phẩm) | Cách dùng & Lưu ý |
|
Cây lâu năm (Sầu riêng, cà phê, tiêu, nhãn...) |
Phòng bệnh | 300 lít nước | Tưới vùng đất dưới tán. Định kỳ 1-2 tháng/lần. Có thể trộn chung với phân hữu cơ, NPK. |
| Trị bệnh | 200 lít nước | Tưới trực tiếp vào gốc theo vùng đất dưới tán cây. | |
|
Cây kiểng / Chậu (Lan, hồng, mai...) |
Phòng bệnh | 300 lít nước | Tưới 1-2 lít dung dịch cho chậu có đường kính 60-80cm. |
| Trị bệnh | 200 lít nước | Tưới đẫm trực tiếp vào gốc. | |
|
Rau màu (Dưa lưới, ớt, bầu bí, hành...) |
Phòng bệnh | 400 lít nước | Tưới đều lên luống. Áp dụng 1-2 lần/vụ. |
| Trị bệnh | 200 lít nước | Tưới trực tiếp vào gốc cây bệnh. |
Lưu ý chung khi sử dụng:
- Thời điểm tưới tốt nhất: Sáng sớm hoặc chiều mát.
- Điều kiện đất: Nên tưới khi đất đã đủ ẩm, tránh tưới khi đất quá khô hoặc bị ngập úng.
- Không sử dụng chung với vôi, thuốc trừ nấm hóa học hoặc thuốc có gốc đồng. Nếu cần dùng, nên cách ly ít nhất 7-10 ngày.
- Nên kết hợp với phân hữu cơ để tăng hiệu quả cải tạo đất và phòng bệnh.

Sử dụng trichoderma xử lý đất
| Trộn đất / Bầu ươm |
• Cây ngắn ngày (Rau): 1kg cho 1000 - 2000m². • Cây lâu năm: 1kg cho 500 - 1000m². |
• Cách dùng: Trộn chung với giá thể (mụn dừa, tro trấu, phân hữu cơ) trước khi vào bầu hoặc rải luống. • Cấm kỵ: Không trộn chung với Vôi bột. |
| Xử lý đất trước khi trồng cây |
1kg trichoderma pha 200 - 400l nước |
Tưới đều trên bề mặt đất trồng |

Sử dụng trichoderma ủ phân chuồng, phân hữu cơ, xử lý rơm rạ
| Phương pháp | Công thức pha trộn | Quy trình kỹ thuật |
|
Ủ phân chuồng (Sản xuất phân hữu cơ vi sinh) |
1-3kg Trichoderma 2-3kg cám gạo (chất dẫn) 500kg phân chuồng + 500kg rơm rạ. |
1. Trộn: Đảo đều nguyên liệu, tưới nước đạt độ ẩm 55-60% (nắm chặt thấy rịn nước). 2. Đống ủ: Cao ~1m, rộng 3-4m. 3. Đảo trộn: 7-10 ngày đảo 1 lần (tổng 2-3 lần). 4. Thời gian: 25-35 ngày. 5. Đạt chuẩn: Hết mùi hôi, phân tơi xốp, mùi chua ngọt. |
|
Phân hủy rơm rạ (Tại ruộng sau thu hoạch) |
Tỷ lệ: • 0.5 - 1kg chế phẩm / 100 lít nước. • Xử lý cho: 2.000m². |
1. Chuẩn bị: Xới đất, tưới ẩm (KHÔNG để ngập nước). 2. Phun: Phun đều dung dịch lên rơm rạ. 3. Chờ: Đợi 5-7 ngày để nấm phân hủy rơm rạ rồi mới làm đất vụ mới. 4. Lợi ích: Không cần đốt rơm rạ. Giảm ngộ độc hữu cơ, giảm lượng phân đạm cần bón cho vụ sau. |
Điều kiện môi trường: Giữ độ ẩm 55-60% (nắm tay thấy nước rỉ ra kẽ ngón tay). Không để quá khô (nấm không nhân lên), quá ướt/ngập nước (nấm chết), hoặc quá nóng (>60°C khi ủ phân).

Xem thêm: Cách ủ phân hữu cơ từ rác nhà bếp bằng trichoderma
Cách ủ tăng sinh khối nấm trichoderma
Phương pháp này dựa trên việc cung cấp một môi trường giàu carbon đơn giản để bào tử nấm nhanh chóng nảy mầm và sinh sôi.
Chuẩn bị nguyên liệu
| Nguyên Liệu | Liều Lượng Tham Khảo | Mục Đích |
| Bột Nấm Trichoderma | 100g - 200g | Nguồn bào tử gốc. |
| Nước Sạch | 10 - 20 lít | Môi trường nhân sinh khối. (Nên dùng nước máy để lắng qua đêm hoặc nước giếng/sông sạch). |
| Thức Ăn (Nguồn Carbon) | 100 - 200g/ml | Thúc đẩy nấm phát triển. |
| Mật rỉ đường (Molasses) | Rất tốt và kinh tế. | |
| Đường ăn (Đường cát) | Dễ kiếm. | |
| Cám gạo (hoặc nước vo gạo đặc) | Cung cấp dinh dưỡng phức hợp. | |
| Dụng Cụ | Thùng/xô sạch, que khuấy. | Đảm bảo dụng cụ không dính hóa chất. |
Các bước thực hiện
-
Hòa tan Dinh Dưỡng: Cho lượng nước sạch đã chuẩn bị vào thùng/xô. Hòa tan hoàn toàn mật rỉ đường/đường ăn (hoặc cám gạo) vào nước.
-
Cấy Nấm: Từ từ rắc bột nấm Trichoderma vào dung dịch đã hòa tan, sau đó khuấy đều.
-
Ủ Hiếu Khí: Đặt thùng ủ ở nơi mát mẻ, tránh ánh nắng trực tiếp và KHÔNG đậy nắp kín (vì nấm Trichoderma là loài hiếu khí, cần oxy để phát triển). Bạn có thể dùng một miếng vải mùng hoặc lưới thưa để che miệng thùng, tránh bụi và côn trùng.
-
Thời gian ủ: Ủ trong khoảng 24 đến 48 giờ.
Dấu hiệu thành công và cách sử dụng
-
Dấu hiệu: Sau thời gian ủ, dung dịch có thể sẽ xuất hiện một lớp màng mỏng, có màu trắng hoặc xanh nhẹ, và có mùi hơi chua nhẹ. Đây là dấu hiệu cho thấy nấm đã nảy mầm và nhân mật độ thành công.
-
Cách sử dụng: Sử dụng dịch nấm gốc này để tưới trực tiếp lên gốc cây hoặc pha loãng thêm với nước sạch để tưới cho diện tích lớn hơn (thường có thể pha loãng dịch gốc này ra thêm 50-100 lít nước nữa).
- Tần suất: Tưới gốc 1-2 lần/vụ (cây ngắn ngày) hoặc 1-2 tháng/lần (cây lâu năm). Phun lá khi thấy dấu hiệu bệnh sớm.
Sử dụng nấm trichoderma đúng cách sẽ giúp cây khỏe mạnh, giảm chi phí cho thuốc bvtv và phân bón hoá học và bảo vệ môi trường.

